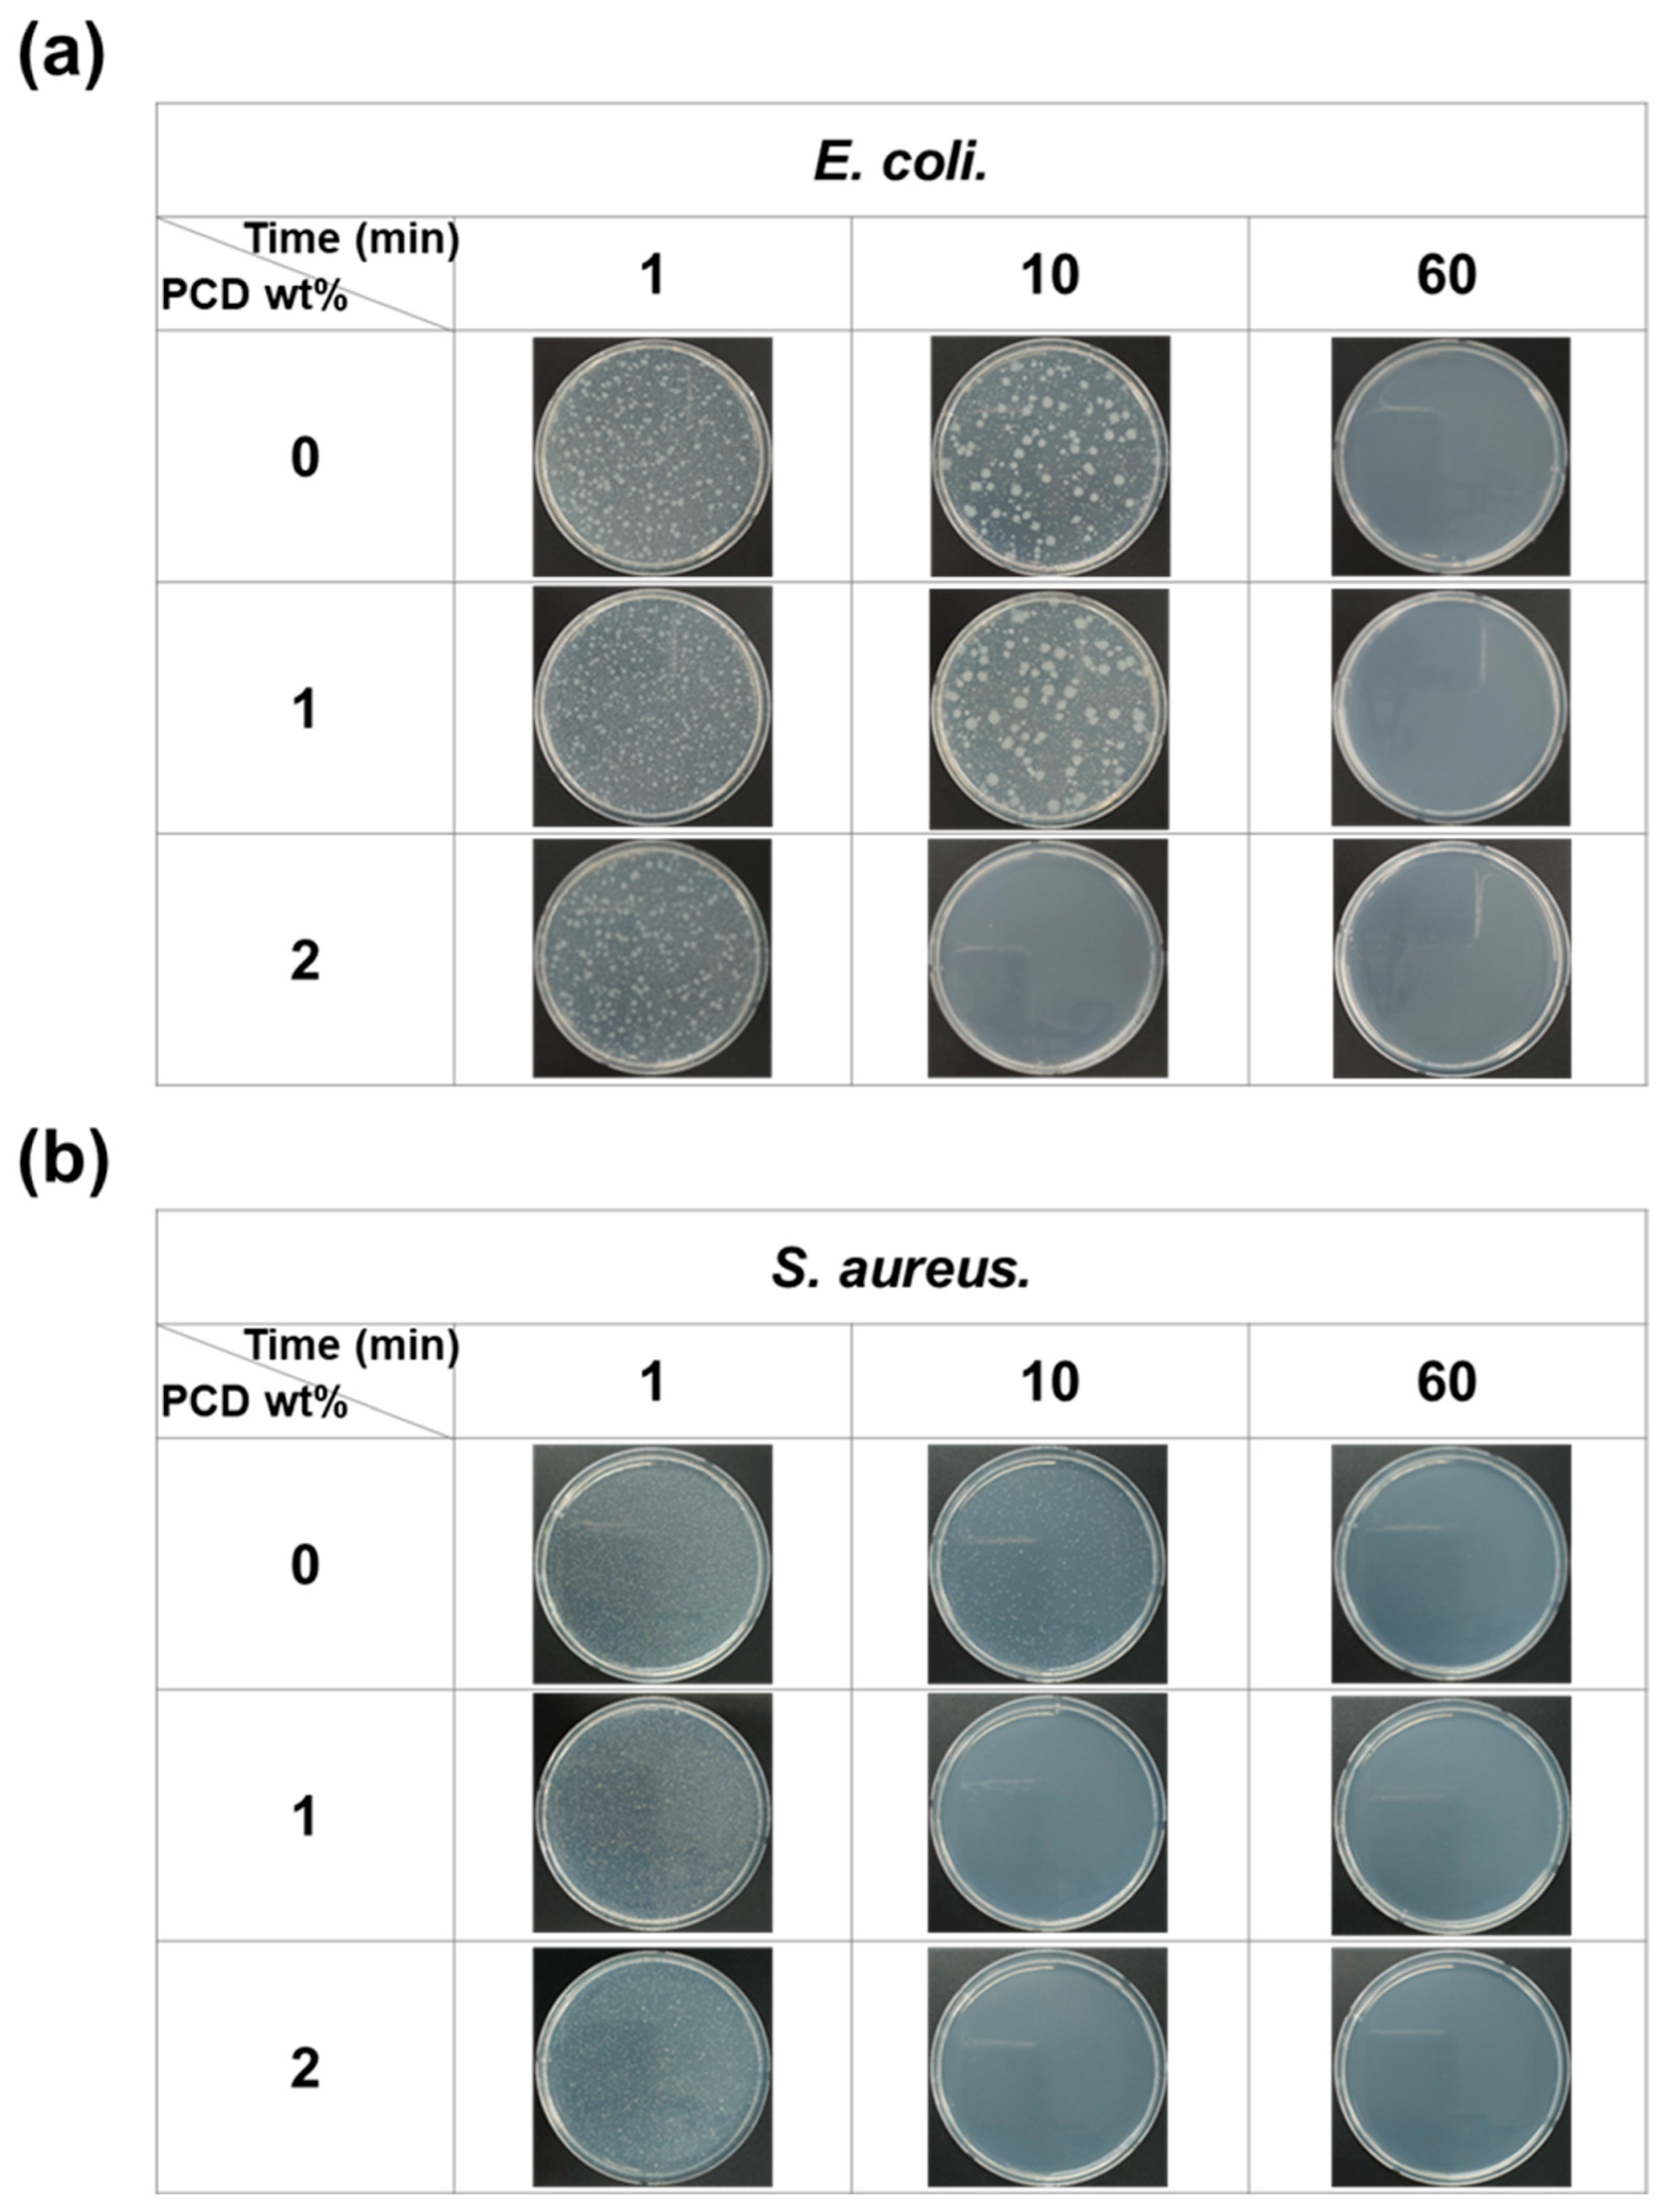
Polymers 17 02792 g004 Polymers 17 02792 g004

Biodegradable PVA–Alginate Bio-Based Polymers Incorporating Cardanol-Based Polyols for Antibacterial Applications
Abstract
1. Introduction
2. Materials and Methods
2.1. Materials
2.2. Preparation
2.2.1. Synthesis of Polyols Derived from Cardanol
2.2.2. Fabrication of Bio-Based Polymers
2.3. Characterization
2.3.1. FT-IR
2.3.2. XRD
2.3.3. TGA
2.3.4. Swelling Test
2.3.5. Antibacterial Test
3. Results and Discussions
3.1. FT-IR of Bio-Based Polymers
3.2. TGA
3.3. Swelling Test
3.4. Antibacterial Test
4. Conclusions
Supplementary Materials
Author Contributions
Funding
Institutional Review Board Statement
Data Availability Statement
Conflicts of Interest
References
- Geyer, R.; Jambeck, J.R.; Law, K.L. Production, Use, and Fate of All Plastics Ever Made. Sci. Adv. 2017, 3, e1700782. [Google Scholar] [CrossRef] [PubMed]
- Costa, J.P.; Mouneyrac, C.; Costa, M.; Duarte, A.C.; Rocha-Santos, T. The Role of Legislation, Regulatory Initiatives and Guidelines on the Control of Plastic Pollution. Front. Environ. Sci. 2020, 8, 104. [Google Scholar] [CrossRef]
- Pilapitiya, P.N.; Ratnayake, A.S. The World of Plastic Waste: A Review. Clean. Mater. 2024, 11, 100220. [Google Scholar] [CrossRef]
- Bin, H.; Wang, S.; Yan, J.; Zhang, H.; Qiu, L.; Liu, W.; Guo, Y.; Shen, J.; Bin, C.; Shi, C.; et al. Review of Waste Plastics Treatment and Utilization: Efficient Conversion and High Value Utilization. Process Saf. Environ. Prot. 2024, 183, 378–398. [Google Scholar] [CrossRef]
- Kim, M.S.; Chang, H.; Zheng, L.; Yan, Q.; Pfleger, B.F.; Klier, J.; Nelson, K.; Majumder, E.L.-W.; Huber, G.W. A Review of Biodegradable Plastics: Chemistry, Applications, Properties, and Future Research Needs. Chem. Rev. 2023, 123, 9915–9939. [Google Scholar] [CrossRef]
- Stoica, M.; Bichescu, C.I.; Crețu, C.-M.; Dragomir, M.; Ivan, A.S.; Podaru, G.M.; Stoica, D.; Stuparu-Crețu, M. Review of Bio-Based Biodegradable Polymers: Smart Solutions for Sustainable Food Packaging. Foods 2024, 13, 3027. [Google Scholar] [CrossRef]
- Pawar, S.N.; Edgar, K.J. Alginate Derivatization: A Review of Chemistry, Properties and Applications. Biomaterials 2012, 33, 3279–3305. [Google Scholar] [CrossRef]
- Patel, M.A.; AbouGhaly, M.H.H.; Schryer-Praga, J.V.; Chadwick, K. The Effect of Ionotripic Gelation Residence Time on Alginate Cross-Linking and Properties. Carbohydr. Polym. 2017, 155, 362–371. [Google Scholar] [CrossRef]
- Raus, R.A.; Wan Nawawi, W.M.F.; Nasaruddin, R.R. Alginate and Alginate Composites for Biomedical Applications. Asian J. Pharm. Sci. 2021, 16, 280–306. [Google Scholar] [CrossRef]
- Puscaselu, R.G.; Lobiuc, A.; Dimian, M.; Covasa, M. Alginate: From Food Industry to Biomedical Applications and Management of Metabolic Disorders. Polymers 2020, 12, 2417. [Google Scholar] [CrossRef]
- Thong, C.C.; Teo, D.C.L.; Ng, C.K. Application of Polyvinyl Alcohol in Cement-Based Composite Materials: A Review of Its Engineering Properties and Micro-Structure Behavior. Constr. Build. Mater. 2016, 107, 172–180. [Google Scholar] [CrossRef]
- Mansur, H.S.; Orefice, R.L.; Mansur, A.A.P. Characterization of Poly(vinyl Alcohol)/Poly(ethylene Glycol) Hydrogels and PVA-Derived Hybrids by Small-Angle X-Ray Scattering and FTIR Spectroscopy. Polymer 2004, 45, 7193–7202. [Google Scholar] [CrossRef]
- Wang, X.; Yucel, T.; Lu, Q.; Hu, X.; Kaplan, D.L. Silk Nanospheres and Microspheres from Silk/PVA Blend Films for Drug Delivery. Biomaterials 2010, 31, 1025–1035. [Google Scholar] [CrossRef] [PubMed]
- Khanna, P.K.; Gokhale, R.R.; Subbarao, V.V.V.S.; Singh, N.; Jun, K.W.; Das, B.K. Synthesis and Optical Properties of CdS/PVA Nanocomposites. Mater. Chem. Phys. 2005, 94, 454–459. [Google Scholar] [CrossRef]
- Zhong, Q.; Shi, G.; Sun, Q.; Mu, P.; Li, J. Robust PVA-GO-TiO2 Composite Membrane for Efficient Separation Oil-in-Water Emulsions with Stable High Flux. J. Membr. Sci. 2021, 640, 119836. [Google Scholar] [CrossRef]
- Liang, X.; Zhong, H.-J.; Ding, H.; Yu, B.; Ma, X.; Liu, X.; Chong, C.-M.; He, J. Polyvinyl Alcohol (PVA)-Based Hydrogels: Recent Progress in Fabrication, Properties, and Multifunctional Applications. Polymers 2024, 16, 2755. [Google Scholar] [CrossRef]
- Wang, M.; Bai, J.; Shao, K.; Tang, W.; Zhao, X.; Lin, D.; Huang, S.; Chen, C.; Ding, Z.; Ye, J. Poly(Vinyl Alcohol) Hydrogels: The Old and New Functional Materials. Int. J. Polym. Sci. 2021, 2021, 2225426. [Google Scholar] [CrossRef]
- Kim, J.O.; Park, J.K.; Kim, J.H.; Jin, S.G.; Yong, C.S.; Li, D.X.; Choi, J.Y.; Woo, J.S.; Yoo, B.K.; Lyoo, W.S.; et al. Development of Polyvinyl Alcohol–Sodium Alginate Gel-Matrix-Based Wound Dressing System Containing Nitrofurazone. Int. J. Pharm. 2008, 359, 79–86. [Google Scholar] [CrossRef]
- Tarun, K.; Gobi, N. Calcium Alginate/PVA Blended Nanofibre Matrix for Wound Dressing. Indian J. Fibre Text. Res. 2012, 37, 127–132. [Google Scholar]
- Kamel, S.; Dacrory, S.; Hesemann, P.; Bettache, N.; Ali, L.M.A.; Postel, L.; Akl, E.M.; El-Sakhawy, M. Wound Dressings Based on Sodium Alginate-Polyvinyl Alcohol-Moringa oleifera Extracts. Pharmaceutics 2023, 15, 1270. [Google Scholar] [CrossRef]
- Motelica, L.; Ficai, D.; Oprea, O.; Ficai, A.; Trusca, R.-D.; Andronescu, E.; Holban, A.M. Biodegradable Alginate Films with ZnO Nanoparticles and Citronella Essential Oil—A Novel Antimicrobial Structure. Pharmaceutics 2021, 13, 1020. [Google Scholar] [CrossRef] [PubMed]
- Voirin, C.; Caillol, S.; Sadavarte, N.V.; Tawade, B.V.; Boutevin, B.; Wadgaonkar, P.P. Functionalization of Cardanol: Towards Biobased Polymers and Additives. Polym. Chem. 2014, 5, 5142–5162. [Google Scholar] [CrossRef]
- Lubi, M.C.; Thachil, E.T. Cashew Nut Shell Liquid (CNSL)—A Versatile Monomer for Polymer Synthesis. Des. Monomers Polym. 2000, 3, 123–153. [Google Scholar] [CrossRef]
- Balachandran, V.S.; Jadhav, S.R.; Vemula, P.K.; John, G. Recent Advances in Cardanol Chemistry in a Nutshell: From a Nut to Nanomaterials. Chem. Soc. Rev. 2013, 42, 427–438. [Google Scholar] [CrossRef]
- Kanehashi, S.; Masuda, R.; Yokoyama, K.; Kanamoto, T.; Nakashima, H.; Miyakoshi, T. Development of a Cashew Nut Shell Liquid (CNSL)-Based Polymer for Antibacterial Activity. J. Appl. Polym. Sci. 2015, 132, 42725. [Google Scholar] [CrossRef]
- Pan, Z.; Ye, H.; Wu, D. Recent Advances on Polymeric Hydrogels as Wound Dressings. APL Bioeng. 2021, 5, 011504. [Google Scholar] [CrossRef]
- Jahan, A.; Masood, S.; Zafar, F.; Shaily; Rizvi, S.A.; Alam, M.; Ghosal, A.; Haq, Q.M.R.; Nishat, N. Development of Cardanol-Based Antibacterial and Anticorrosive Bio-Polyurea-Epoxy Composite Coating for Mild Steel Surface. Prog. Org. Coat. 2024, 189, 108273. [Google Scholar] [CrossRef]
- Wang, T.; Zhang, F.; Zhao, R.; Wang, C. Polyvinyl Alcohol/Sodium Alginate Hydrogels Incorporated with Silver Nanoclusters via Green Tea Extract for Antibacterial Applications. Des. Monomers Polym. 2020, 23, 118–133. [Google Scholar] [CrossRef]
- Rafiq, M.; Hussain, T.; Abid, S.; Nazir, A.; Masood, R. Development of Sodium Alginate/PVA Antibacterial Nanofibers by the Incorporation of Essential Oils. Mater. Res. Express 2018, 5, 035007. [Google Scholar] [CrossRef]
- Lee, D.H.; Song, Y.H.; Ahn, H.J.; Lee, J.; Woo, H.C. Fabrication and Characterization of Biopolymers Using Polyvinyl Alcohol and Cardanol-Based Polyols. Molecules 2024, 29, 4807. [Google Scholar] [CrossRef]
- Ahn, H.J.; Kang, K.S.; Song, Y.H.; Lee, D.H.; Kim, M.H.; Lee, J.K.; Woo, H.C. Effect of Cardanol Content on the Antibacterial Films Derived from Alginate-PVA Blended Matrix. Clean Technol. 2022, 28, 24–31. [Google Scholar]
- Abral, H.; Atmajaya, A.; Mahardika, M.; Hafizulhaq, F. Effect of ultrasonication duration of polyvinyl alcohol (PVA) gel on characterizations of PVA film. J. Mater. Res. Technol. 2020, 9, 2477–2486. [Google Scholar] [CrossRef]
- Afshar, M.; Dini, G.; Vaezifar, S.; Mehdikhani, M.; Movahedi, B. Preparation and Characterization of Sodium Alginate/Polyvinyl Alcohol Hydrogel Containing Drug-Loaded Chitosan Nanoparticles as a Drug Delivery System. J. Drug Delivery Sci. Technol. 2020, 56, 101530. [Google Scholar] [CrossRef]
- Xu, Y.; Xu, Y.; Sun, C.; Zou, L.; He, J.W. The preparation and Characterization of Plasticized PVA Fibres by A novel Glycerol/Pseudo Ionic Liquids System with Melt Spinning Method. Eur. Polym. J. 2020, 133, 109768. [Google Scholar] [CrossRef]
- Yang, W.; Qi, G.; Kenny, J.M.; Puglia, D.; Ma, P. Effect of Cellulose Nanocrystals and Lignin Nanoparticles on Mechanical, Antioxidant and Water Vapour Barrier Properties of Glutaraldehyde Crosslinked PVA Films. Polymers 2020, 12, 1364. [Google Scholar] [CrossRef]
- Wang, H.; Zhang, R.; Zhang, H.; Jiang, S.; Liu, H.; Sun, M.; Jiang, S. Kinetics and Functional Effectiveness of Nisin Loaded Antimicrobial Packaging Film Based on Chitosan/Poly(vinyl alcohol). Carbohydr. Polym. 2015, 127, 64–71. [Google Scholar] [CrossRef]
- Raptopoulos, G.; Choinopoulos, I.; Kontoes-Georgoudakis, F.; Paraskevopoulou, P. Polylactide-Grafted Metal-Alginate Aerogels. Polymers 2022, 14, 1254. [Google Scholar] [CrossRef]
- Cardenas-Jiron, G.; Leal, D.; Matsuhiro, B.; Osorio-Roman, I. Vibrational Spectroscopy and Density Functional Theory Calculations of Poly-D-Mannuronate and Heteropolymeric Fractions from Sodium Alginate. J. Raman Spectrosc. 2011, 42, 870–878. [Google Scholar] [CrossRef]
- Sakugawa, K.; Ikeda, A.; Takemura, A.; Ono, H. Simplified Method for Estimation of Composition of Alginates by FTIR. J. Appl. Polym. Sci. 2004, 93, 1372–1377. [Google Scholar] [CrossRef]
- Xiao, Q.; Gu, X.; Tan, S. Drying Process of Sodium Alginate Films Studied by Two-dimensional Correlation ATR-FTIR Spectroscopy. Food Chem. 2014, 164, 179–184. [Google Scholar] [CrossRef] [PubMed]
- Liu, Z.; Chen, J.; Knothe, G.; Nie, X.; Jiang, J. Synthesis of Epoxidized Cardanol and Its Antioxidative Properties for Vegetable Oils and Biodiesel. ACS Sustain. Chem. Eng. 2016, 4, 901–906. [Google Scholar] [CrossRef]
- Li, S.; Yang, X.; Huang, K.; Li, M.; Xia, J. Design, Preparation and Properties of Novel Renewable UV-Curable Copolymers Based on Cardanol and Dimer Fatty Acids. Prog. Org. Coat. 2014, 77, 388–394. [Google Scholar] [CrossRef]
- Shukla, P.; Srivastava, D. Reaction Kinetics of Esterification of Phenol-Cardanol Based Epoxidized Novolac Resins and Methacrylic Acid. Int. J. Plast. Technol. 2014, 18, 1–15. [Google Scholar] [CrossRef]
- Hu, Y.; Shang, Q.; Bo, C.; Jia, P.; Feng, G.; Zhang, F.; Liu, C.; Zhou, Y. Synthesis and Properties of UV-Curable Polyfunctional Polyurethane Acrylate Resins from Cardanol. ACS Omega 2019, 4, 12505–12511. [Google Scholar] [CrossRef]
- Choi, D.; Khan, M.H.; Jung, J. Crosslinking of PVA/Alginate Carriers by Glutaraldehyde with Improved Mechanical Strength and Enhanced Inhibition of Deammonification Sludge. Int. Biodeterior. Biodegrad. 2019, 145, 104788. [Google Scholar] [CrossRef]
- Li, X.; Shu, M.; Li, H.; Gao, X.; Long, S.; Hu, T.; Wu, C. Strong, Tough and Mechanically Self-Recoverable Poly(Vinyl Alcohol)/Alginate Dual-Physical Double-Network Hydrogels with Large Cross-Link Density Contrast. RSC Adv. 2018, 8, 16674–16689. [Google Scholar] [CrossRef]
- Rudra, R.; Kumar, V.; Kundu, P.P. Acid Catalysed Cross-Linking of Poly(Vinyl Alcohol) (PVA) by Glutaraldehyde: Effect of Crosslink Density on the Characteristics of PVA Membranes Used in Single Chambered Microbial Fuel Cells. RSC Adv. 2015, 5, 83436–83447. [Google Scholar] [CrossRef]
- Meng, W.; Zhang, X.; Zhang, Y.; Zhang, X. Poly(Vinyl Alcohol)/Sodium Alginate Polymer Membranes as Eco-Friendly and Biodegradable Coatings for Slow Release Fertilizers. J. Sci. Food Agric. 2023, 103, 3592–3601. [Google Scholar] [CrossRef]
- Freire, T.F.; Quinaz, T.; Fertuzinhos, A.; Quyền, N.T.; de Moura, M.F.S.M.; Martins, M.; Zille, A.; Dourado, N. Thermal, Mechanical and Chemical Analysis of Poly(Vinyl Alcohol) Multifilament and Braided Yarns. Polymers 2021, 13, 3644. [Google Scholar] [CrossRef]
- Aydın, A.A.; Ilberg, V. Effect of Different Polyol-Based Plasticizers on Thermal Properties of Polyvinyl Alcohol: Starch Blends. Carbohydr. Polym. 2016, 136, 441–448. [Google Scholar] [CrossRef]
- Yang, J.M.; Yang, J.H.; Tsou, S.C.; Ding, C.H.; Hsu, C.C. Cell Proliferation on PVA/Sodium Alginate and PVA/Poly(γ-Glutamic Acid) Electrospun Fiber. Mater. Sci. Eng. C 2016, 66, 170–177. [Google Scholar] [CrossRef]
- Siddaramaiah; Swamy, T.M.M.; Ramaraj, B.; Lee, J.H. Sodium Alginate and Its Blends with Starch: Thermal and Morphological Properties. J. Appl. Polym. Sci. 2008, 109, 4075–4081. [Google Scholar] [CrossRef]
- Rodrigues, F.H.A.; Souza, J.R.R.; França, F.C.F.; Ricardo, N.M.P.S.; Feitosa, J.P.A. Thermal Oligomerisation of Cardanol. e-Polymers 2006, 6, 1–14. [Google Scholar] [CrossRef]
- Kamoun, E.A.; Kenawy, E.R.S.; Tamer, T.M.; El-Meligy, M.A.; Eldin, M.S.M. Poly(Vinyl Alcohol)-Alginate Physically Crosslinked Hydrogel Membranes for Wound Dressing Applications: Characterization and Bio-Evaluation. Arabian J. Chem. 2015, 8, 38–47. [Google Scholar] [CrossRef]
- Shivakumara, L.R.; Demappa, T. Synthesis and Swelling Behavior of Sodium Alginate/Poly(Vinyl Alcohol) Hydrogels. Turk. J. Pharm. Sci. 2019, 16, 252–260. [Google Scholar] [CrossRef] [PubMed]
- Salem, D.M.S.A.; Sallam, M.A.E.; Youssef, T.N.M.A. Synthesis of Compounds Having Antimicrobial Activity from Alginate. Bioorg. Chem. 2019, 87, 103–111. [Google Scholar] [CrossRef] [PubMed]
- Asadpoor, M.; Ithakisiou, G.-N.; van Putten, J.P.M.; Pieters, R.J.; Folkerts, G.; Braber, S. Antimicrobial Activities of Alginate and Chitosan Oligosaccharides Against Staphylococcus aureus and Group B Streptococcus. Front. Microbiol. 2021, 12, 700605. [Google Scholar] [CrossRef] [PubMed]
- Yumin, A.; Liguo, D.; Yi, Y.; Yongna, J. Mechanical Properties of an Interpenetrating Network Poly(vinyl alcohol)/Alginate Hydrogel with Hierarchical Fibrous Structures. RSC Adv. 2022, 12, 11632–11639. [Google Scholar] [CrossRef]
- Mansur, H.S.; Sadahira, C.M.; Souza, A.N.; Mansur, A.A.P. Ftir Spectroscopy Characterization of Poly (Vinyl Alcohol) Hydrogel with Different Hydrolysis Degree and Chemically Crosslinked with Glutaraldehyde. Mater. Sci. Eng. C 2008, 28, 539–548. [Google Scholar] [CrossRef]
- Pandit, A.H.; Mazumdar, N.; Imtiyaz, K.; Rizvi, M.M.A.; Ahmad, S. Periodate-Modified Gum Arabic Cross-Linked PVA Hydrogels: A Promising Approach toward Photoprotection and Sustained Delivery of Folic Acid. ACS Omega 2019, 4, 16026–16036. [Google Scholar] [CrossRef]

Disclaimer/Publisher’s Note: The statements, opinions and data contained in all publications are solely those of the individual author(s) and contributor(s) and not of MDPI and/or the editor(s). MDPI and/or the editor(s) disclaim responsibility for any injury to people or property resulting from any ideas, methods, instructions or products referred to in the content. |
© 2025 by the authors. Licensee MDPI, Basel, Switzerland. This article is an open access article distributed under the terms and conditions of the Creative Commons Attribution (CC BY) license (https://creativecommons.org/licenses/by/4.0/).
Share and Cite
Lee, D.H.; Ahn, H.J.; Lee, J.; Woo, H.C. Biodegradable PVA–Alginate Bio-Based Polymers Incorporating Cardanol-Based Polyols for Antibacterial Applications. Polymers 2025, 17, 2792. https://doi.org/10.3390/polym17202792
Lee DH, Ahn HJ, Lee J, Woo HC. Biodegradable PVA–Alginate Bio-Based Polymers Incorporating Cardanol-Based Polyols for Antibacterial Applications. Polymers. 2025; 17(20):2792. https://doi.org/10.3390/polym17202792
Chicago/Turabian StyleLee, Da Hae, Hee Ju Ahn, Jaekyoung Lee, and Hee Chul Woo. 2025. "Biodegradable PVA–Alginate Bio-Based Polymers Incorporating Cardanol-Based Polyols for Antibacterial Applications" Polymers 17, no. 20: 2792. https://doi.org/10.3390/polym17202792
APA StyleLee, D. H., Ahn, H. J., Lee, J., & Woo, H. C. (2025). Biodegradable PVA–Alginate Bio-Based Polymers Incorporating Cardanol-Based Polyols for Antibacterial Applications. Polymers, 17(20), 2792. https://doi.org/10.3390/polym17202792







